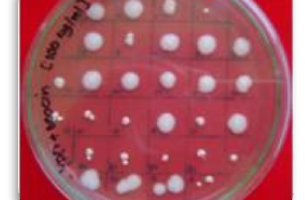

Erithropoietin (rhEPO)
Nama Produk Teknologi Erithropoietin (rhEPO) Inventor Dr. Adi Santoso Deskripsi Produk / Teknologi Protein farmasetik…

Nama Produk Teknologi Erithropoietin (rhEPO) Inventor Dr. Adi Santoso Deskripsi Produk / Teknologi Protein farmasetik…

Nama Produk Teknologi Tekknologi Penepungan Ubi Kayu Kaya Beta-Karoten Dan Protein Inventor Ahmad Fathoni M.Sc.;…

Cibinong, Humas LIPI. Lembaga Ilmu Pengetahuan Indonesia (LIPI) berkolaborasi dengan L’Oreal Foundation dalam kegiatan sosialisasi terkait aplikasi pengajuan…
Nama Produk Teknologi Produk Bahan Baku Obat Biosimilar Human Granulocyte-Colony Stimulating Factor (hG-CSF) Inventor Dr.…
Pengantar Transfer embrio (TE) merupakan generasi kedua bioteknologi reproduksi setelah inseminasi buatan (IB). Teknologi ini…
Latar belakang Nata de coco sebenarnya adalah selulosa murni produk kegiatan mikroba Acetobacter xylinum. Produk…
